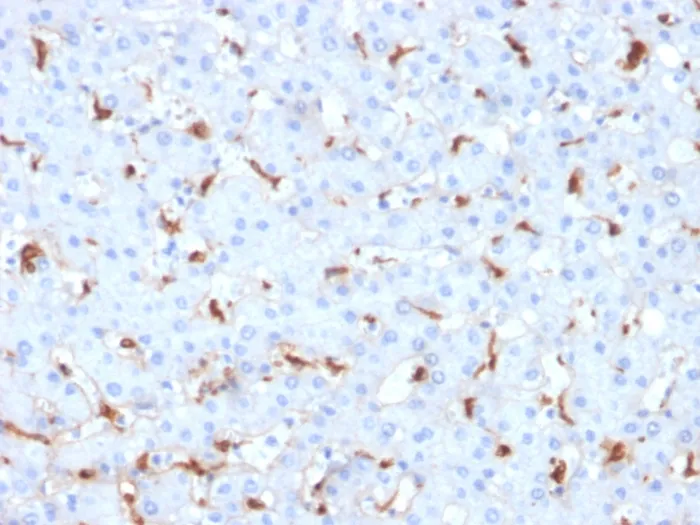
Anti-C1QB / Complement C1q B-Chain(C1QB/2961), Biotin conjugate - image 1

Anti-C1QB / Complement C1q B-Chain(C1QB/2961), Biotin conjugate
- Availability: 24/48H Stock Items & 2 to 6 Weeks non Stock Items.
- Dry Ice Shipment: No

Anti-C1QB / Complement C1q B-Chain(C1QB/2961), Biotin conjugate
Description:
Complement C1q B Chain (C1qb) is a subunit of C1q. C1q is composed of 6 polypeptide chains each of C1qa, C1qb, and C1qc. C1q is a component of the classical complement pathway, and thereby plays an important role in the immune response. Each C1q subunit contains an N-terminal collagen-like region and a C-terminal C1q globular domain. The presence of receptors for C1q on effector cells modulates its activity, which may be antibody-dependent or independent. Macrophages are the primary source of C1q, while anti-inflammatory drugs as well as cytokines differentially regulate expression of the mRNA as well as the protein. C1q deficiency is associated with lupus erythematosus and glomerulonephritis. Primary antibodies are available purified, or with a selection of fluorescent CF® Dyes and other labels. CF® Dyes offer exceptional brightness and photostability. Note: Conjugates of blue fluorescent dyes like CF®405S and CF®405M are not recommended for detecting low abundance targets, because blue dyes have lower fluorescence and can give higher non-specific background than other dye colors.Synonyms:
C1QB; Complement component 1 q subcomponent B chain; Complement component C1q B chainUNSPSC:
41116161UNSPSC Description:
Primary and secondary antibodies for multiple methodology immunostaining detection applicationGene Name:
C1QBGene ID:
713NCBI Gene ID:
8986UniProt:
P02746Cellular Locus:
Secreted (extracellular)Host:
MouseSpecies Reactivity:
HumanImmunogen:
Recombinant fragment (around aa 41-188) of human C1QB protein (exact sequence is proprietary)Target Antigen:
C1QB | Complement C1q B-ChainClonality:
MonoclonalIsotype:
IgG1 κClone:
C1QB/2961Conjugation:
BiotinSource:
AnimalApplications:
IHC, FFPE (verified)Validated Applications:
IHC, FFPEField of Research:
ImmunologyPositive Control:
Human liver, kidney or brain tissue (IHC).Concentration:
0.1 mg/mLBuffer:
PBS, 0.1% BSA, 0.05% azideMolecular Weight:
26-29 kDaShipping Conditions:
Room temperatureStorage Conditions:
4°C; Stable at room temperature or 37°C (98°F) for 7 days.Shelf Life:
2 yearsCAS Number:
9007-83-4
DATASHEET Document
View DocumentMSDS Document
View Document